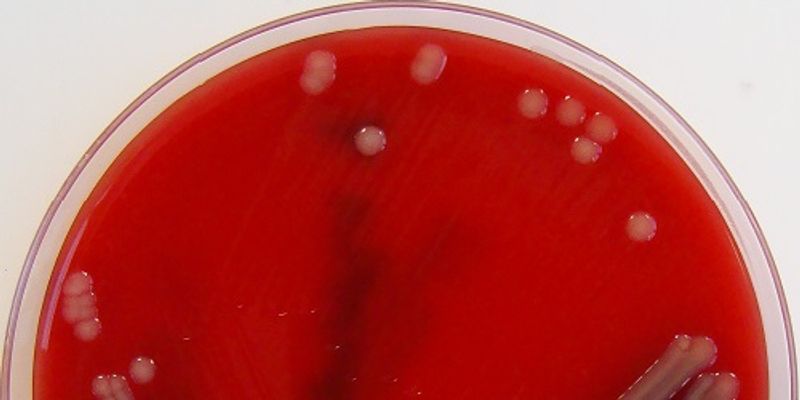

Blood Culture
Blood culture is a diagnostic test that checks for pathogens (e.g., bacteria, yeast) in the blood which can result from having a blood infection that can affect the entire body. A blood sample is taken from the patient and grown in broth media for bacteria to grow and be analyzed.
What's Popular in Blood Culture
-
JAN 10, 2024MicrobiologyRespiratory syncytial virus (RSV) is a common infection that can affect children and senior adults. Symptoms can include ...Written By: Carmen LeitchNOV 21, 2023Genetics & GenomicsInsulin regulates blood sugar, and it is made by cells in the pancreas called beta cells. Type 1 diabetes arises when so ...Written By: Carmen LeitchNOV 13, 2023Drug Discovery & DevelopmentNew study reveals an unexpected phenomenon of virologic rebound and prolonged contagiousness post-recovery in Paxlovid t ...Written By: Amielle MorenoSEP 25, 2023Clinical & Molecular DXImmunoassays are methods for detecting and quantifying analytes within a biological sample based on specific antigen-ant ...SEP 14, 2023CardiologyWomen can be particularly negatively affected by overtraining and undereating.Written By: Savannah Logan
JAN 10, 2024
Microbiology
Respiratory syncytial virus (RSV) is a common infection that can affect children and senior adults. Symptoms can include
...
Written By:
Carmen Leitch
NOV 21, 2023
Genetics & Genomics
Insulin regulates blood sugar, and it is made by cells in the pancreas called beta cells. Type 1 diabetes arises when so
...
Written By:
Carmen Leitch
NOV 13, 2023
Drug Discovery & Development
New study reveals an unexpected phenomenon of virologic rebound and prolonged contagiousness post-recovery in Paxlovid t
...
Written By:
Amielle Moreno
SEP 25, 2023
Clinical & Molecular DX
Immunoassays are methods for detecting and quantifying analytes within a biological sample based on specific antigen-ant
...
SEP 14, 2023
Cardiology
Women can be particularly negatively affected by overtraining and undereating.
Written By:
Savannah Logan
SEP 03, 2023
Microbiology
Our bodies are host to trillions of microbes, many of which live in our gastrointestinal tract. Those gut microbes are c
...
Written By:
Carmen Leitch
AUG 15, 2023
Microbiology
Abstract In this study, we used Sartorius Real-time PCR kits for the rapid detection of bacteria, fungi, and mycoplasma
...
AUG 03, 2023
Microbiology
The gut microbiome is home to trillions of microorganisms, which have been shown to have a dramatic impact on many aspec
...
Written By:
Carmen Leitch
JUL 17, 2023
Drug Discovery & Development
Introduction Antibodies are the ideal therapeutic biomolecules due to their ability to bind to a variety of targets with
...
-
JAN 20, 2026 | 9:15 AMBloodstream infections (BSIs) remain a critical challenge in clinical care, where every hour of delay in diagnosis can significantly impact patient outcomes. This webinar explores findings f...NOV 06, 2025 | 12:00 PMIn this innovation-focused webinar, we’ll explore how syndromic testing is transforming the diagnostic and clinical management of bloodstream infections (BSIs). Featuring real-world ex...Candida auris is a serious emerging public health threat due to its multi-drug resistance and the ability to spread in healthcare facilities. In addition, it is challenging and time consumin...Speaker: Sarah Elliott, PhD , Sherry Dunbar, PhD, MBA
AUG 28, 2024 | 9:00 AM
C.E. CREDITS
Blood Cultures are the gold standard test for Sepsis diagnosis and an essential first step in infectious organism identification. Improving its quality is critical to the outcomes for a pati...
MAY 31, 2023 | 10:00 AM
Date: May 31, 2023 Time: 10:00am (PDT), 1:00pm (EDT), 5:00pm (CEST) Bloodstream infections (BSIs) are defined as a systemic infection resulting from the presence of viable microorganisms in...
JAN 20, 2026 | 9:15 AM
Bloodstream infections (BSIs) remain a critical challenge in clinical care, where every hour of delay in diagnosis can significantly impact patient outcomes. This webinar explores findings f...
NOV 06, 2025 | 12:00 PM
In this innovation-focused webinar, we’ll explore how syndromic testing is transforming the diagnostic and clinical management of bloodstream infections (BSIs). Featuring real-world ex...
Candida auris is a serious emerging public health threat due to its multi-drug resistance and the ability to spread in healthcare facilities. In addition, it is challenging and time consumin...
Speaker:
Sarah Elliott, PhD
, Sherry Dunbar, PhD, MBA
AUG 28, 2024 | 9:00 AM
C.E. CREDITS
Blood Cultures are the gold standard test for Sepsis diagnosis and an essential first step in infectious organism identification. Improving its quality is critical to the outcomes for a pati...
MAY 31, 2023 | 10:00 AM
Date: May 31, 2023 Time: 10:00am (PDT), 1:00pm (EDT), 5:00pm (CEST) Bloodstream infections (BSIs) are defined as a systemic infection resulting from the presence of viable microorganisms in...
FEB 15, 2023 | 7:00 AM
Date: February 15, 2023 Time: 7:00am (PST), 10:00pm (EST), 4:00pm (CET) While not all microscopy samples can fluoresce, all can scatter light, and this scattered light can be imaged. This ha...
Speaker:
Philipp Kukura
, Francesco Reina
, Matthew Kose-Dunn
, Phil Allen
Sponsored By: Teledyne Photometrics
Date: December 07, 2022 Time: 11:00am (PST), 2:00pm (EST), 8:00pm (CET) The success of blood cultures is dependent on the collection of uncontaminated specimens, culture of a large volume of...
DEC 07, 2022 | 9:00 AM
Date: December 07, 2022 Time: 9:00am (PST), 12:00pm (EST), 6:00pm (CET) Join us for an exciting live panel webinar, as we celebrate the 60th anniversary of Gibco Cell Culture. The panelists...
Speaker:
Jessica Hess
, Rukia Henry
, Ernesto Goulart
, Ameet Chimote, PhD
Sponsored By: Thermo Fisher Scientific/Gibco
NOV 01, 2022 | 9:00 AM
Date: November 1, 2022 Time: 9:00am (PDT), 12:00pm (EDT), 5:00pm (CET) Rapid and efficient organism identification and antimicrobial susceptibility reports are paramount for patient survival...
-
MARCH 7, 2025Featuring emerging trends, new applications, and workflow solutions-Where Solutions Deliver Results!...APR 26, 2023 | 9:00 AM PDTIn this Lab Week virtual symposium, bioMérieux celebrates Medical Laboratory Professionals by providing education and learning opportunities to support the life-changing work you and your lab...DEC 07, 2021 | 12:00 PM PSTDate: December 7, 2021 Time: 12:30-5:00 p.m. ET #NCATS10...Each step in a diagnostic test's journey-from raw material extraction to patient administration-can influence outcomes....MAR 16, 2021 | 5:00 AM PDTJoin the two-Day Virtual IVD Conference on advancing immunoassay tech and performance Making an in vitro diagnostic assay has never been easy. Now with the global lab and supply chain and di...
MARCH 7, 2025
Featuring emerging trends, new applications, and workflow solutions-Where Solutions Deliver Results!...
APR 26, 2023
| 9:00 AM PDT
In this Lab Week virtual symposium, bioMérieux celebrates Medical Laboratory Professionals by providing education and learning opportunities to support the life-changing work you and your lab...
DEC 07, 2021
| 12:00 PM PST
Date: December 7, 2021 Time: 12:30-5:00 p.m. ET #NCATS10...
Each step in a diagnostic test's journey-from raw material extraction to patient administration-can influence outcomes....
MAR 16, 2021
| 5:00 AM PDT
Join the two-Day Virtual IVD Conference on advancing immunoassay tech and performance Making an in vitro diagnostic assay has never been easy. Now with the global lab and supply chain and di...
SEP 29, 2020
| 8:00 AM PDT
2nd ANNUAL PAWS FOR A CURE VIRTUAL EVENT RESEARCH SYMPOSIUM Translational Potential Of Comparative Approaches To Accelerate Drug Development In Shared Childhood & Canine Cancers We are...
SEP 01, 2020
| 10:30 AM
This 2-day virtual event organized across the Asia Pacific region aims to serve as a platform to share scientific knowledge and provide a discourse on the topic of infectious disease and imm...
JUN 16, 2020
Mass Spectrometry has come a long way over the years and has brought powerful analytical capability to a wide range of applications. Behind every powerful mass spec is a powerful mind workin...
FEB 27, 2019
| 6:00 AM PST
Labroots and the Drug Discovery planning committee are pleased to announce its 2nd annual event in the Drug Discovery Virtual Event Series....